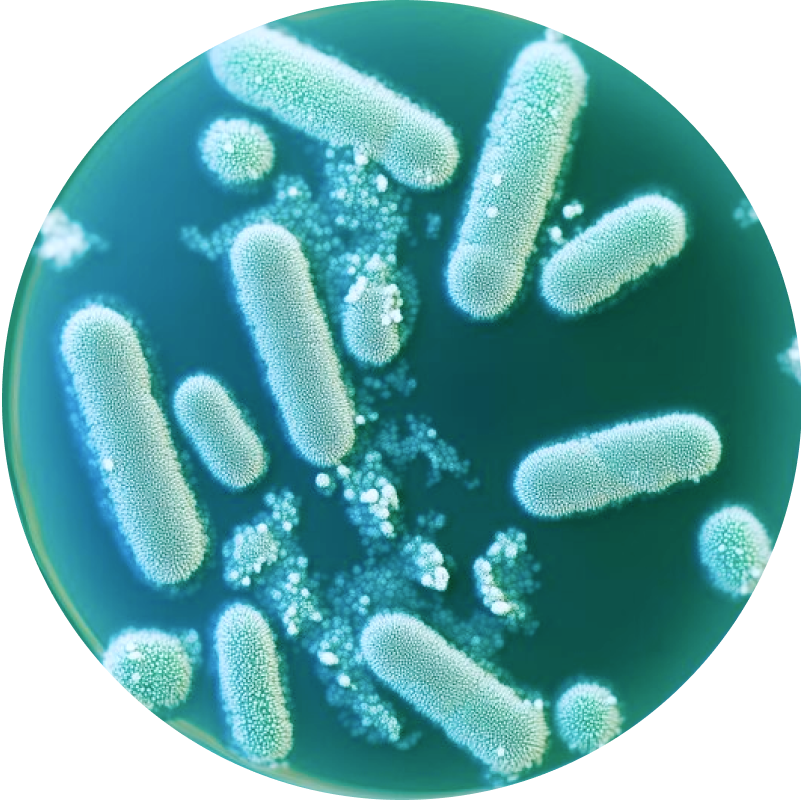

WHAT MAKES PAWSBIOTIC SO EFFECTIVE?
PawsBiotic’s functional pet products are scientifically formulated by top veterinarians, nutritionists and researchers to stop your dog’s most common health issues at their source. BetterWild takes cutting-edge veterinary science and combines it with the most effective natural ingredients to help relieve your dog of their allergies, digestive issues and joint troubles. Our goal is to help your dog live the happiest, healthiest, longest life possible.